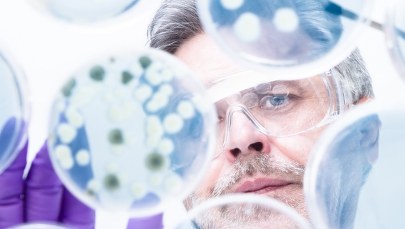
​Naukowcy podczas III Igrzysk Europejskich zbadają mikrobiom Krakowa

Reprezentacja Polski, osłabiona brakiem kilku czołowych zawodniczek, uplasowała się na czwartej pozycji podczas pierwszego turnieju mistrzostw Europy w Algarve. Podopieczne Janusza Urbanowicza pokazały bardzo dobre rugby, co znakomicie wróży przed zbliżającymi się III Igrzyskami Europejskimi Kraków-Małopolska 2023.
Jeśli chodzi o skład, którym jedziemy do Portugalii, to nie ma z nami Anny Klichowskiej i Karoliny Jaszczyszyn. Małgorzata Kołdej wróciła po kontuzji mięśniowej, ale nie jest jeszcze w pełni sprawna, podobnie jak Julianna Schuster, której dokucza Achilles, ale również jedzie z nami - mówił przed rozpoczęciem turnieju Janusz Urbanowicz, który musiał borykać się ze sporymi problemami kadrowymi, bo pomniejsze urazy miały także Natalia Pamięta i Katarzyna Paszczyk.
Szkoleniowiec biało-czerwonych bardzo chłodno podchodził do turnieju w Algarve, zapowiadając, że będzie zadowolony, jeśli jego podopieczne uplasują się na piątej pozycji w mistrzostwach Europy, bo to pozwoli im za rok ponownie powalczyć o udział w World Series.
Reprezentacja Polski zaczęła od mocnego uderzenia i w swoim pierwszym spotkaniu rozbiła Rumunię 43:5. Cieszyć mogło nie tylko samo zwycięstwo, ale fakt, że w dobrej formie zaprezentowały się Kołdej, Paszczyk i Pamięta, a więc zawodniczki, o których zdrowie się obawialiśmy. Znów dobrze zaprezentowała się będąca od początku sezonu w dobrej formie Ilona Zaiszliuk i nasza drużyna udanie rozpoczęła turniej w Algarve.
Rumunki już znamy, miałyśmy kilka okazji, by się z nimi zmierzyć, chociażby ostatnio w Benidormie. Wygrałyśmy wysoko, nasza gra była poukładana, pojawiły się małe błędy, ale są do wyeliminowania - mówiła tuż po spotkaniu Julia Druzgała.
Trochę nerwów było za to w spotkaniu z Czeszkami, z którymi nasza drużyna zaczęła bardzo źle i przegrywała już 0:14. Tuż przed przerwą pierwsze przyłożenie zaliczyła Paszczyk, ale nie udało się podwyższyć i po pierwszej połowie sytuacja Polek była nieciekawa. Jednak po zmianie stron biało-czerwone ruszyły do ataku i po przyłożeniu Julii Druzgały oraz udanym podwyższeniu zbliżyły się do rywalek na dwa "oczka", a następnie dorzuciły kolejne pięć punktów autorstwa Kołdej i wygrały to trudne spotkanie 17:14.
Ostatni mecz z Czeszkami przegrałyśmy i bardzo obawiałyśmy się tego spotkania. To było ciężkie starcie, psychicznie i fizycznie, ale udało się wygrać, choć przegrywałyśmy do przerwy. To nasz sukces, cieszymy się z dobrego początku mistrzostw Europy - powiedziała na zakończenie pierwszego dnia rywalizacji Hanna Maliszewska.
Sobota dla reprezentacji Polski zaczęła się od bardzo trudnego meczu z Belgią, która była rewelacją Challengera do World Series w RPA i po raz pierwszy od dawna, w bezpośrednim starciu to rywalki zdawały się faworytkami. Biało-czerwone wyszły jednak na ten mecz niezwykle zmotywowane i po dwóch przyłożeniach Kołdej do przerwy prowadziły 10:0.
Po zmianie stron diablice ruszyły do ataku, ale nawet mimo gry w osłabieniu naszej drużyny, która spotkanie kończyła w szóstkę, były w stanie tylko raz zameldować się na naszym polu punktowym. Polki zdołały wcześniej odpowiedzieć tym samym i finalnie nasza drużyna zwyciężyła 17:7, wygrywając grupę A, a przede wszystkim odbudowując morale po poprzednich turniejach.
Jesteśmy mega szczęśliwe, że wygrałyśmy z Belgią. Po naszych występach w RPA miałyśmy coś do udowodnienia, więc tym bardziej nas to cieszy. To był fantastyczny mecz w naszym wykonaniu. Bardzo agresywnie grałyśmy w obronie, przez co Belgijki popełniały błędy. Mecz układał się pod nasze dyktando i z tego powodu jesteśmy bardzo zadowolone - oceniła Tamara Czumer-Iwin.
O tym, że biało-czerwone coraz bardziej przypominają drużynę, która przed rokiem sięgnęła po złoto, przekonały się w ćwierćfinale Niemki, które właściwie już po pierwszej połowie straciły nadzieję na awans. Pierwsza akcja spotkania przyniosła Polkom siedem punktów. Najpierw Zaiszliuk rozbiła defensywę przeciwniczek, a następnie Patrycja Zawadzka pomknęła przez pół boisko i przyłożyła między słupami, ułatwiając zadanie kopiącej Pamięcie.
Przed przerwą na polu punktowym meldowały się jeszcze Sylwia Witkowska i Paszczyk, a biało-czerwone prowadziły 19:0, odbierając Niemkom ochotę do gry. Janusz Urbanowicz dokonał kilku zmian, ale gra naszej drużyny wcale nie ucierpiała. Choć rywalki na moment nacisnęły, co akcję w swoim stylu przeprowadziła Kołdej, która po sprincie niemal od własnego pola punktowego zaliczyła kolejne przyłożenie dla naszej drużyny, okraszone punktami z podwyższenia Pamięty.
Spotkanie świetną indywidualną akcję spuentowała Julianna Schuster, która również ostatnio miała problemy ze zdrowiem, ale w tym spotkaniu pokazała, że jest już w dobrej dyspozycji i jako dżoker sprawdza się idealnie. Polki wygrały ostatecznie 31:0, demolując rywalki i zgłaszając akcje do walki o medale.
W półfinale naszymi rywalkami były zawodniczki z Wielkiej Brytanii, które zaczęły to spotkanie bardzo dobrze, bo szybko zdobyły przyłożenie, po którym udanie kopnęły na słupy. Biało-czerwone odpowiedziały po akcji formacji młyna i wejściu Kołdej, która tym razem przebiegła zaledwie kilka metrów. Natalia Pamięta po podwyższeniu wyrównała na 7:7 i... to było niestety na tyle, jeśli chodzi o Polki.
W czwartej minucie pierwszej połowy żółtą kartką ukarana została Sylwia Witkowska i podopieczne Janusza Urbanowicza musiały radzić sobie w osłabieniu. To niestety sprawiło, że do przerwy przegrywaliśmy 7:21 po dwóch kolejnych przyłożeniach rywalek.
W drugiej części gry Polki kilka razy próbowały przebić się pod pole punktowe Brytyjek, ale te pokazały, że są świetnie dysponowane fizycznie i mocno szarżowały czy to Kołdej czy Paszczyk. Naszym przeciwniczkom udało się dwukrotnie zameldować na naszym polu punktowym i ostatecznie wygrały 31:7, pewnie awansując do finału.
Rywalki wykorzystały nasze błędy, na tym polega ta gra. To spotkanie mimo wszystko napawa optymizmem, choć wynik tego nie oddaje. Jeśli wyeliminujemy tych kilka błędów, następnym razem wynik może być inny - powiedziała po tym spotkanie Małgorzata Kołdej.
Polkom pozostało spotkanie o trzecie miejsce i rywalizacja z Irlandią, która uległa Francji 0:29
Pierwsza połowa starcia z Irlandkami zaczęła się od przewagi naszego zespołu, który po trzech minutach spuentował ją siedmiopunktową akcją. Przez środek defensywy rywalek przedarła się Natalia Pamięta, która położyła piłkę między słupami, a po chwili dopełniła formalności, dorzucając dwa "oczka" po przyłożeniu.
Kiepski początek nieco rozbudził reprezentację Irlandii, która zaczęła coraz częściej dochodzić do głosu. Niestety dla nas żółtą kartką ukarana została Hanna Maliszewska, przez co Polki musiały kończyć tę część gry w osłabieniu. Rywalkom udało się przedrzeć na nasze pole punktowe, ale nie wykorzystały podwyższenia i do przerwy biało-czerwone prowadziły 7:5.
Niestety druga połowa zaczęła się dla biało-czerwonych niezbyt dobrze, bo po szarży prawym skrzydłem kolejne pięć punktów dołożyła Kate Farrell. Na nasze szczęście przeciwniczki ponownie nie potrafiły zmieścić piłki między słupami i prowadziły tylko 10:7.
Chwilę później, za sprawą Beibhinn Parsons, drużyna Irlandii po raz trzeci zameldowała się na naszym polu punktowym, podwyższając swoje prowadzenie i stawiając Polki w bardzo niekorzystnej sytuacji. Niestety podopieczne Janusza Urbanowicza nie potrafiły w drugiej odsłonie przełamać defensywy rywalek, na dodatek zaczęły popełniać sporo własnych błędów i ostatecznie przegrały 7:20, kończąc turniej w Algarve na czwartej pozycji.
W finale Francja pokonała Wielką Brytanię 19:7, dzięki czemu przed drugim turniejem, który zostanie rozegrany w Hamburgu w dniach 7-9 lipca ma spore szanse na tytuł mistrzyń Europy. Biało-czerwone cały czas pozostają w grze o medale i miejmy nadzieję, że w Niemczech uda im się odrobić straty
Teraz przed reprezentacją Polski kilka dni przerwy, po której kadra przeniesie się do Krakowa, gdzie w dniach 25-27 czerwca na Stadionie Miejskim im. Henryka Reymana odbędzie się rywalizacja w ramach III Igrzysk Europejskich. Będzie to walka nie tylko o medale tej prestiżowej imprezy, ale również olimpijską kwalifikację. Bezpośredni bilet do Paryża wywalczą złote medalistki, natomiast drugi i trzeci zespół awansują do turnieju interkontynentalnego. Stawka jest więc bardzo wysoka.
Po turnieju w Algarve znamy już rozstawienie grup podczas III Igrzysk Europejskich. W grupie A zagrają Wielka Brytania, Czechy, Włochy i niżej sklasyfikowany po turnieju w Zagrzebiu z duetu Turcja - Norwegia. Wyżej sklasyfikowany wystąpi w grupie B, gdzie spotka się z Polską, Niemcami i Portugalią. W grupie C zobaczymy Hiszpanię, Belgię, Szwecję i Rumunię.